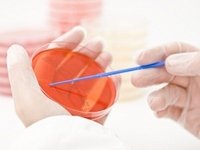

Выявление уреаплазмы уреалитикум у женщин говорит о том, что у неё уреаплазмоз.
Это инфекция с половым путем передачи.
Она вызывает симптомы уретрита.
Может осложнять течение беременности.
При длительном течении может вызывать болезнь Рейтера.
- Что такое уреаплазма уреалитикум
- Инкубационный период уреаплазмы уреалитикум у женщин
- Симптомы уреаплазмы уреалитикум у женщин
- ПЦР для выявления уреаплазмы у женщин
- Уреаплазма уреалитикум: какие иммуноглобулины определяются в крови
- Посев на уреаплазму с чувствительностью к антибиотикам
- Нормы уреаплазмы уреалитикум и парвум у женщин
- Показания к лечению уреаплазмоза
- Схемы лечения уреаплазма уреалитикум и парвум у женщин
- Контрольные анализы после лечения уреаплазмоза
Что такое уреаплазма уреалитикум
Это мелкая бактерия.
Она может обитать в структурах урогенитального тракта.
Воспалительные поражения глотки или прямой кишки не вызывает.
Во время орального или анального секса не передается.
Инфицирование происходит только при вагинальном контакте.
Первично поражается уретра, реже – влагалище.
Есть два вида бактерий рода уреаплазма, которые паразитируют в мочеполовых путях.
Это U. parvum и U. urealyticum.
Первая более патогенная.
Она чаще выявляется при уретритах.
Вторая – чаще не вызывает симптомов.
Она нередко обнаруживается во влагалище на фоне бактериального вагиноза.
Оба вида уреаплазм ассоциируются с осложнениями беременности.
Факторы патогенности бактерий:
- Уреазная активность.
При участии уреаплазм образуется аммиак.
Он оказывает цитотоксическое воздействие на клетки.
С их помощью уреаплазма прикрепляется к клеткам.
Они играют решающую роль при передаче инфекции.
В основном уреаплазма находится на поверхности эпителиоцитов.
Она также может прикрепляться к эритроцитам и сперматозоидам.
Вместе с мужскими половыми клетками проникает в матку и фаллопиевы трубы.
Поэтому часто у женщин выделяются уреаплазмы их этих органов.
Но выраженные признаки их воспаления обычно не развиваются.
При наличии воспалительных поражений органов малого таза уреаплазмы, как правило, выявляются в сочетании с другими микроорганизмами.
Адгезины обладают антигенными свойствами.
Они провоцируют иммунные реакции.
Эти факторы патогенности обусловливают негативное влияние уреаплазмы уреалитикум у женщин на течение беременности.
При инфицировании плода они вызывают выработку простагландинов.
Это одна из причин самопроизвольных абортов до 16 недели.
Уреаплазмы могут расщеплять белки.
В первую очередь протеазы необходимы для уничтожения иммуноглобулинов А.
Это иммунные факторы человеческого организма, которые необходимы для защиты от бактерий.
В свою очередь бактерии защищаются от них при помощи протеаз.
Инкубационный период уреаплазмы уреалитикум у женщин
Симптомы после заражения появляются не сразу.
Проходит около 1 месяца между незащищенным сексом и возникновением первых клинических признаков патологии.
Причем, появляется симптоматика далеко не всегда.
У женщин 20-40 лет часто признаки не появляются длительное время.
У них инкубационный период уреаплазмоза может продолжаться несколько месяцев.
Среди этой возрастной категории часто встречаются бессимптомные формы.
В то время как у женщин до 20 лет, а также после 45 лет симптомы обычно присутствуют.
На длительность инкубационного периода влияет ряд факторов.
Это состояние биоценоза влагалища, иммунитет, прием препаратов или их местное использование, наличие сопутствующих половых инфекций.
Симптомы уреаплазмы уреалитикум у женщин
В большинстве случаев уреаплазмоз не сопровождается выраженной клинической симптоматикой.
Инфекция обычно поражает уретру. В ней возникают воспалительные реакции.
Начинаются выделения. Они необильные, слизистые. В уретре может ощущаться зуд.
При осмотре отмечается отечность и покраснение.
В 70% случаев никаких жалоб у пациентки нет.
Симптомы могут выявляться лишь при объективном осмотре.
Нередко даже объективно признаки инфекции не обнаруживаются.
Если при этом лабораторными методами выявляются уреаплазмы, такое состояние называют не уреаплазмозом, а уреаплазмоносительством.
Оно тоже в некоторых случаях подлежит лечению.
Например, по эпидемиологическим показаниям (при смене партнера, чтобы не заразить его) или при планировании беременности.
ПЦР для выявления уреаплазмы у женщин
Основа диагностики уреаплазмоза – это ПЦР.
Причина заключается в том, что:
- симптомы инфекции не являются патогномоничными – они встречаются при любых других уретритах;
- бактерия очень маленькая, и в микроскоп её увидеть нельзя;
- на питательных средах уреаплазма растет несколько дней, к тому же, такая диагностика обходится дороже;
- анализы крови на антитела не всегда достоверны, а потому не могут использоваться для подтверждения активной инфекции.
ПЦР позволяет выявить уреаплазму даже в минимальных концентрациях.
Подтверждается не только уреаплазмоз, но и уреаплазмоносительство.
При необходимости можно получить количественные показатели.
Они имеют немаловажное значение, потому что уреаплазма не всегда вызывает симптомы воспаления.
При малом количестве в урогенитальном тракте лечение может не проводиться.
Кроме того, терапия может выполняться не до полного уничтожения уреаплазм, а с целью снижения их количества до определенного уровня.
С другой стороны, многие врачи ставят под сомнение целесообразность проведения количественных исследований на уреаплазму.
До сих пор нет убедительных доказательств, свидетельствующих, что в малых концентрация уреаплазма уреалитикум или парвум у женщин менее опасна, чем в больших.
Показаниями для обследования являются:
- симптомы уретрита у женщин;
- подготовка к беременности;
- подготовка к ЭКО;
- определение причин бесплодия;
- донорство яйцеклеток;
- суррогатное материнство;
- перинатальные потери в анамнезе;
- наличие признаков воспаления в мазке на флору.
Мазки берут из влагалища, уретры и цервикса.
Обследуют обычно женщин методом ПЦР не только на уреаплазмоз.
Потому что это диагноз исключения.
Его можно ставить лишь в том случае, если симптомы воспаления есть, а других патогенов в уретре кроме уреаплазмы нет.
В первую очередь необходимо удостовериться в отсутствии инфекций, вызывающих схожие симптомы.
К ним относятся:
Если возбудители других ЗППП не обнаружены, а уреаплазмы выявлены, диагностируется уреаплазменная инфекция.
При наличии признаков воспаления (клинических или лабораторных) подтверждается уреаплазмоз.
Если воспалительного процесса нет, констатируется бактерионосительство.
Тогда решение о необходимости лечения принимается индивидуально.
Уреаплазма уреалитикум: какие иммуноглобулины определяются в крови
Ещё одним методом диагностики уреаплазмоза является анализ крови на антитела.
Это вспомогательный тест, а не основной.
Он может применяться лишь:
- в рамках скрининга – для массового обследования женщин;
- для уточнения характера течения инфекции (вместе с ПЦР).
Для скрининга кровь обычно берут сразу на несколько инфекций.
Если к каким-либо из них, включая уреаплазмоз, выявляются антитела, диагноз не ставится.
Требуется подтверждающий тест.
Таковым может быть ПЦР или бакпосев.
Анализ крови на антитела к уреаплазме применяется для уточнения данных других исследований.
В частности, метод позволяет установить давность инфицирования и активность воспалительного процесса.
Для этого определяются в крови иммуноглобулины разных классов, обычно М и G.
Антитела класса М начинают определяться в крови в небольших титрах уже через неделю после заражения женщины уреаплазмой.
Через 2 месяца они исчезают.
Иммуноглобулины G появляются через 2 недели в крови.
Их титр постепенно нарастает.
После затухания активной фазы инфекции титр снижается.
Но полностью G не исчезают до тех пор, пока есть в организме уреаплазма.
Даже после излечения иммуноглобулины G выявляются в течение нескольких месяцев, а иногда определяются ещё несколько лет.
Таким образом, выводы на основании анализов можно сделать следующие:
- При наличии IgМ и отсутствии IgG – инфицирование произошло совсем недавно, сейчас идет инкубационный период.
- При наличии IgG и IgМ – острая фаза инфекции, с момента заражения прошло не больше 2 месяцев.
- При наличии IgG и отсутствии IgМ – хроническая или перенесенная в недавнем прошлом инфекция.
- При отсутствии обоих классов иммуноглобулинов – инфекции нет, либо заражение произошло меньше 1 недели назад.
Оценивается также уровень IgG в динамике.
При его возрастании в течение 2 недель в 4 раза говорят об активной уреаплазменной инфекции.
Результаты анализов крови не всегда достоверны.
Иногда они дают ложноположительные или отрицательные результаты.
Сроки появления антител тоже могут отличаться у некоторых людей.
Особенно в случае наличия ВИЧ или других иммунодефицитов.
Посев на уреаплазму с чувствительностью к антибиотикам
Бакпосев – ещё один способ диагностики уреаплазмы уреалитикум у женщин.
В широкой практике он не применяется.
Суть метода состоит в том, что материал помещается на питательную среду.
На ней вырастают колонии.
Их идентифицируют по внешнему виду, способности расщеплять мочевину или аргинин.
Проводится также определение чувствительности к антибиотикам.
В большинстве случаев уреаплазмы чувствительны к:
- доксициклину;
- эритромицину;
- джозамицину;
- азитромицину;
- левофлоксацину;
- доксициклину.
Хотя к любому из этих препаратов может быть резистентность.
Она бывает первичной и вторичной.
Первичная – это когда женщина заражается уже резистентной флорой.
Вторичная – когда бактерия становится нечувствительной к антибиотику уже после инфицирования.
Обычно это происходит по причине самолечения.
Для преодоления антибиотикорезистентности используются различные способы.
Один из них – назначение посева на уреаплазмы.
Если инфекция не поддается терапии, делают культуральное исследование с определением чувствительности к антибиотикам.
После этого выдаются результаты, и врач знает уже через несколько дней, к каким препаратам уреаплазма не имеет чувствительности.
Из схемы терапии эти лекарственные средства исключаются.
Назначаются только те, которые могут воздействовать на данную бактерию.
Такая схема терапии с высокой вероятностью приводит к успеху.
Нормы уреаплазмы уреалитикум и парвум у женщин
Мы уже говорили о том, что некоторые исследования дают количественные результаты.
При ПЦР определяется количество копий ДНК бактерий в материале.
При посеве количество оценивается в колониеобразующих единицах.
Но в настоящее время нет убедительных доказательств, что концентрация уреаплазмы парвум или уреалитикум на что-то влияет.
Вряд ли по количественным показателям можно оценивать:
- целесообразность назначения лечения;
- успех проводимой терапии;
- возможность отмены лечения;
- риск осложнений;
- вероятность неблагоприятного исхода беременности и т.д.
Общепринятым для большинства бактерий является показатель 10 в 4 степени КОЕ или копий ДНК.
Такой же используется и для уреаплазмоза.
Но пока что нет доказательств, что, к примеру, самопроизвольные аборты чаще случаются у тех женщин, у кого уреаплазмы выделяются в большей концентрации.
И причины тому очевидны:
- концентрация бактерий – показатель динамичный, а не статичный, он может быстро меняться;
- количество микроорганизмов в соскобе клеток не определяет его общее количество в организме (очагов воспаления может быть много);
- количество может значительно отличаться в разных участках уретры или влагалища.
Таким образом, данный показатель необъективен.
Большинство врачей его уже не используют.
Никаких норм уреаплазмы в урогенитальном тракте не существует.
Показания к лечению определяются, исходя из других параметров, к числу которых концентрация бактерий не относится.
Показания к лечению уреаплазмоза
Показаниями к назначению терапии уреаплазмоза у женщин являются:
- наличие признаков воспаления урогенитального тракта – клинических или лабораторных;
- бактериальный вагиноз;
- смена полового партнера;
- подготовка к беременности;
- подготовка к донорству яйцеклеток;
- предстоящие инвазивные процедуры или операции на половых органах.
Так как наибольшую опасность уреаплазменная инфекция представляет для беременных женщин, то в первую очередь в лечении нуждаются молодые пациентки.
В том числе те, кто не собирается беременеть в ближайшее время.
Все равно рано или поздно желание завести ребенка может появиться.
А уреаплазмы никуда не денутся – лечиться перед беременностью все равно придется.
Так лучше избавиться от этих патогенов сразу, чтобы:
- при случайной беременности избежать осложнений;
- не заражать половых партнеров;
- не допустить развития бесплодия, болезни Рейтера или других осложнений.
Лечение можно не проводить только тем пациенткам, которые:
- не ведут половую жизнь или живут во взаимно моногамном браке;
- никогда не планируют менять полового партнера;
- никогда не планируют беременеть.
При этом должны отсутствовать симптомы воспаления.
Тогда лечение не проводится.
Но факт уреаплазмоносительства отмечается.
В будущем, если у женщины возникнут воспалительные процессы во влагалище, врач уже будет знать, на что стоит её проверять, и от чего лечить.
Схемы лечения уреаплазма уреалитикум и парвум у женщин
Основа терапии – это антибиотики.
Их обычно применяют курсом от 3 до 7 дней.
Назначают один из препаратов таких фармакологических групп:
На практике чаще используются первые две.
К ним бактерии более чувствительные.
Реже используются фторхинолоны.
В основном их назначают как препараты резерва.
Лечение уреаплазмы уреалитикум у женщин чаще всего проводится по одной из двух схем:
- доксициклин по 100 мг в сутки;
- джозамицин по 500 мг, дважды в день.
У беременных используются только макролиды.
Обычно это джозамицин.
При исчезновении симптомов лечение женщины все равно продолжают.
Потому что клинического выздоровления недостаточно – нужно выздоровление микробиологическое.
Необходимо пройти весь курс, назначенный врачом.
Контрольные анализы после лечения уреаплазмоза
Контроль назначается через месяц после приема последней дозы антибиотика.
Используется обычно ПЦР.
Также врач обследует женщину.
Он смотрит, есть ли признаки воспаления.
Берется мазок на флору, проверяется количество лейкоцитов.
При неэффективности терапии может потребоваться повторный курс антибиотиков.
Назначаются препараты другой группы.
По показаниям проводится бакпосев для оценки чувствительности уреаплазмы парвум к антибактериальным препаратам.
Для повторного курса назначаются те из них, к которым бактерия имеет самую высокую восприимчивость.
При подозрении на уреаплазму уреалитикум обращайтесь к автору этой статьи – венерологу в Москве с многолетним опытом работы.
- ВИЧ
- Гарднереллез
- Кондиломатоз
- Молочница
- Сифилис
- Трихомониаз
- Баланопостит
- Герпес
- Гонорея
- Микоплазмоз
- Уреаплазмоз
- Уретрит
- Хламидиоз
- ЗППП
Сегодня я хочу поговорить с Вами об одном из заболеваний современного человечества-уреаплазмозе. Читайте внимательно статья написана практикующим врачом. Проводя исследование мочеиспускательного канала у мужчин и цервикального канала у женщин в современных диагностический лабораториях у многих пациентов выявляется уреаплазма. Выставляется диагноз уреаплазменная инфекция нижних мочевых путей и пациенту назначается курс мощнейших антибиотиков от этой хвори. Мало того дополнительно назначаются средства для улучшения обмена веществ, витамины, препараты для улучшения иммунитета.
Пациент в недоумении. Половых контактов на стороне не было. Вторая половина клянется в верности, однако врач настаивает на лечении паравенерического заболевания. Так как правильно ответить на вопрос- нужно ли лечить уреаплазму??
Мне все еще встречаются пары без всяких жалоб, которые обратились к врачам по поводу планирования беременности. Им был выставлен грозный диагноз уреаплазмоз.
Идем дальше как поступить при выявлении данных микроорганизмов в соскобе методом ПЦР. Не претендуя на истину в последней инстанции, мы считаем, что при отсутствии признаков воспаления, и нормальное количество лейкоцитов в мазке проводимом методом световой микроскопии уреаплазму лечить не надо. Это мировой опыт ведущих венерологов в мире.
Если Вас интересует вопрос -возможно ли заразиться уреаплазмозом при поцелуе или оральном контакте, то это вполне возможно, но таким образом Вы можете быть инфицированным намного более грозными заболеваниями.
Возможно, гипердиагностика и демонизация уреаплазмоза культивируется фармокологическими фирмами производителями препаратов от данной патологии. Они используют огромные ресурсы, позволяющие навязывать мнение как пациентам так и врачам.
Старайтесь выбирать своего лечащего врача работающего с позиции доказательной медицины, но это в совсем другая история…
Все об уреаплазмозе
Роль ur. urealiticum
Роль ur. urealiticum. в возникновении заболеваний мочеполовой сферы до сих пор до конца не выяснена. Тем не менее при обследовании пациентов методом ПЦР с жалобами на бесплодие, болями тазовой области, различными дизурическими проявлениями (боль или дискомфорт при мочеиспускании), вагинальными белями достаточно часто выявляется только уреаплазма.
Существует и ряд пациентов, у которых нет практически никаких жалоб, но также обнаруживающих уреаплазму в своих результатах исследования на ЗППП. И потому на данный момент у докторов урологов, гинекологов, венерологов нет единого подхода к лечению уреаплазмы.
Лечить ли уреаплазму
Так лечить ли доктору уреаплазму у своих пациентов? В данной работе мы ведем речь лишь об ur.ur., которая является одним из видов рода mycoplasme. Уреаплазма выявляется более чем в 80% у лиц в период наибольшей сексуальной активности 18-45 лет. У мужчин с хроническим простатитом около 53%. У пациенток с рецидивирующим циститом чуть более 40% случаев. У женщин с хроническими тазовыми болями в 50%, у женщин с эндометритом в 38% случаев (по результатам собственных исследований, обследовано 200 пациентов 40-мужчин, 160 – женщин).
Интересно, что у тех пациенток, у которых по результатам опроса зафиксировано более 1 партнера, как правило, были активные жалобы при обнаружении уреаплазмы, а у женщин имеющих 1 постоянного партнера или не живущих в настоящее время половой жизнью жалоб не наблюдалось. Также хотелось бы отметить, что выраженная клиника была у пациентов с так называемой микетовой инфекцией. То есть когда этих же пациентов дополнительно обследовали методом ПЦР на вирусы, а также им проводился бактериальный посев на выявление бактериальных инфекций, было обнаружено у 50% обследуемых пациенток с хроническими белями кроме уреаплазмы какие-то другие бактерии, вирусы или грибы, но по клинике, характеру жалоб этих женщин соответствовали уреаплазме. Это позволяет предположить, что есть определенные катализаторы (то есть ускорители) данной инфекции. При наличии каких-либо других бактерий, уреаплазма себя активно проявляет и находится в инертном состоянии, если она изолирована в организме.
Ведение пациентов с уреаплазмой
Безусловно , важен и иммунный компонент организма пациентки, то есть при разбалансированности иммунитета человек и болеет тяжелее с яркими клиническими проявлениями. Исходя из вышеизложенного, определим для себя ключевые моменты при ведении пациентов с уреаплазмой. Всех пациентов, вне зависимости от вариантов клиники (выраженная или стертая) обследовать дополнительно на вирусы, грибы и бактерии. При выявлении случаев микстовой инфекции, акцент в лечении должен делаться на повышение иммунитета, восстановление флоры, проводится комплексная терапия всех выявленных бактерий. Всегда обследуется и лечится половой партнер женщины.
Лечением полового партнера занимается уролог. При выявлении изолированной ur.ur. и при наличии любых клинических симптомов, характерных для уреаплазмы, лечение проводится обязательно. При выявлении изолированной ur.ur. при первичном обследовании и при отсутствии какой-либо клиники, жалоб у пациентки, нужно соотнести ее с группами риска (количество половых партнеров, заболевания мочеполовой сферы в анамнезе, планируемая беременность). Так, если перед вами пациентка с отсутствием клиники, но планирующая беременность в ближайшие 4-6 месяцев, лечите такую пациентку в любом случае, так как невозможно предугадать особенности течения предстоящей беременности.
Уреаплазма и беременность
Напряженный иммунитет и обострение соматической патологии во время беременности, как правило, приводит и к обострению инфекции. Поэтому задача врача сводится к минимализации рисков предстоящей беременности. Если у пациентки, обратившейся к гинекологу впервые выявлена ur.ur., но нет жалоб, ее необходимо пролечить в паре, так как она может быть «резервуаром» для инфекции и и причиной простатита у мужчин. Только в одном случае не рекомендуем лечить пациентку с обнаруженной изолированной уреаплазмой. Если вы пролечили ее и ее единственного партнера, у них обоих отсутствует какая-либо клиника, пара не планирует беременность, но вновь обнаруживается ur.ur. при повторном обследовании. Оправданным считается повторное обследование в сроки 1,5-2 месяца методов ПЦР. Критерием излеченности также может служить бактериальный посев на уреаплазму (количественно, всё, что ниже 10 в 6 степени будет являться нормой для данной пары).
Лечение уреаплазмоза, микоплазмоза в Уфе
Лечение в Уфе уретритов, вызванных микоплазмами и уреаплазмами.
Последнее время увеличивается частота и значение урогенитальных и микоплазменных инфекций, возникновений уретритов у мужчин. Заболевание передается при половых сношениях. Чаще всего воспалительные заболевания уретры у мужчин протекают хронически. Наиболее часто в мазках из уретры выделяются микоплазмы и уреаплазмы. Внешне хронические уретриты могут ничем не проявляться и протекают малосимптомно. От момента заражения до появления первых признаков проходит 50-60 дней. Уретриты у мужчин могут проявляться зудом, жжение в мочеиспускательном канале, выделения из мочеиспускательного канала обычно незначительные и появляются большей частью по утрам. При поражении простатической части уретры наблюдаются урологические расстройства в мочеиспускании и мочеполовых функциях (учащении и усилении позывов на мочеиспускание, боль в конце акта мочеиспускания, болезненные эякуляции, в некоторых случаях примесь крови и гноя спермы). При нарушениях правила забора мазка уретры и нарушении правил транспортировки, отделяемого уретры возможны ложно отрицательные результаты, с чем связаны некоторые сложности выяления хронических уретритов у мужчин. Повторные анализы после провокации химической или пищевой обычно решают эту проблему. Лечение проводится антибиотиками широкого спектра действий, длительными курсами. В некоторых случаях добавляется местное лечение в виде инсцилляций уретры лекарственных веществ, а также введение антибиотиков с помощью аппарата ИНТРАМАГ. При лечении хронических уретритов у мужчин принципиальным является лечение половой парнерши (половых партнерш), даже если у них отсутствуют видимые проявления болезни. При длительном течении заболевания как правило развивается хронический простатит.
Все что нужно знать о уреаплазмозе
Нужно ли лечить уреаплазмоз? Этот вопрос возникает как и у мужчин, так и у женщин, которым был поставлен такой диагноз. Лечат уреаплазму в обязательном порядке, когда она находится в острой стадии, и сопровождается следующей симптоматикой:
- болезненное, тянущее ощущение в нижней части живота;
- обильные выделения из половых органов (мутноватые, могут быть как с запахом, так и без него);
- наружные половые органы и влагалище подвержены зуду и жжению.
Важно! Нередко такую клиническую картину можно спутать с гарднереллой или молочницей, хламидиозом или микоплазмой, именно поэтому сдача мазка из влагалища поможет поставить точный диагноз.
А надо ли лечить уреаплазму, если анализ показал ее наличие, а симптоматики нет? Бытует мнение, что с этим можно повременить, т. к. были случаи когда недуг проходил сам по себе. Верное это мнение или нет — над этим вопросом спорят десятки врачей. Лечение уреаплазмоза снимет с вас статус носителя этой бактерии, но и прием большого количества медикаментов принесет больший вред, чем ее наличие в организме. Но без лечения в России обычно не обойтись, если:
- пациентка готовится к операции или сложной медицинской манипуляции;
- есть сложности с вынашиванием беременности;
- случаются частые аборты;
- у пациентки диагностировано женское заболевание половой сферы в хронической форме.
Важно! В российской медицине в последние годы принято, что если анализ показал наличие уреаплазмозной бактерии в количестве менее 10 в 4 степени, то с лечением можно повременить. Но если значение превышает эту цифру, то лечение нужно начать в кратчайшие сроки.
Уреаплазма у женщин: может ли пройти сама?
Нужно ли лечить уреаплазму или она может пройти сама? Этот вопрос интересует многих, но ответить на него однозначно невозможно, а все потому, что до конца это заболевание не изучено. Но согласно медицинской практике и врачебному опыту относительно уреаплазмоза у женщин стоит сказать следующее:
- При проведении анализа по вертикальному инфицированию «мать-ребенок» у новорожденных женского пола на наличие клеточного паразита, к которому относится небольшой, но опасный микроорганизм Ureaplasma urealyticum, треть из них всегда положительны. Причем паразитарные бактерии поражают слизистые дыхательной и половой системы или оседают на эпидермисе. И всего лишь 5% школьниц, которые не живут половой жизнью, имеют эти бактерии. Это показатель намного меньше, чем при первичном вертикальном анализе, а это говорит о том, что самоизлечение организма от бактерии возможно. Ведь изначально речь идет о 30%, по данным роддома, и 5% — после школьного осмотра.
- Мало шансов на самоизлечение при проникновении бактериального паразита через половой контакт. Иногда на появление первых симптомов, как жжение и зуд, уйдет от нескольких дней до месяца. А бывает, что сиптоматика так и не появляется. А если проникновение бактерии произошло оральным путем, то в ближайшее время разовьется ангина и вся симптоматика, которая ей свойственна. Лечение будет направлено на устранение ее симптомов, и вылеченная женщина решит, что все прошло, но это не так. Инфекция закрепляется на слизистых оболочках. И все это буквально до сильного стресса, переохлаждения или другого негативного обстоятельства, когда бактерия начнет активную деятельность, что проявится в неприятных и болезненных симптомах.
Важно! При обдумывании вопроса «необходимо ли лечение уреаплазмы у женщин или она все-таки пройдет сама», подумайте, что коварный недуг может годами не показывать себя, а вы все это время будете активным носителем инфекции.
Можно ли от уреаплазмы вылечиться навсегда?
Нередко пациентки задают своему гинекологу вопрос о том, можно ли вылечить уреаплазму полностью и навсегда. При попадании в женский организм эта бактерия может стать первопричиной, таких болезней, как:
- цистит;
- воспалительный кольпит;
- пиелонефрит;
- эндометрит.
И если произошло образование такого тандема, то полностью вылечить организм от этих недугов будет очень непросто, ведь бактерия попала в эндометрий всех внутренних органов. Но если будет подобрана грамотная схема лечения уреаплазмы и больная вовремя обратится к врачу, то полностью избавиться от уреаплазмы можно. Однако это не гарантирует, что это навсегда, ведь исключить вторичное инфицирование невозможно.
Нередко при сильном иммунитете у зараженного на уреаплазмоз патогенный возбудитель будет вялым, а значит и протекать будет бессимптомно. И это может длиться годы, а человек и не будет знать, что он заражен. Но это не помешает ему заражать других, ведь он носитель инфекции, не знающий об этом.
Факты о Ureaplasma urealyticum
Чтобы понять насколько коварна уреаплазма, и длительным ли будет ваше лечение от этого недуга, нелишним будет узнать важные факты о Ureaplasma urealyticum:
- Эта бактерия относится к самым мелким прокариотам, свободно перемещающимся и размножающимся в организме, являясь при это паразитом. Она может длительное время висеть на клеточной мембране, тесно взаимодействуя с ней. При этом бактерия будет строить свою колонию, попадая под защиту клетки.
- При длительном контакте патогенной флоры и клеточного слоя организма возникает симбиоз, который скрывает ее от воздействия иммунной системы или антибактериальных препаратов.
- Когда решают чем лечить уреаплазму и сколько это будет длиться, нужно помнить о том, что она склонна к мутации, которая происходит постоянно. Поэтому подобрать эффективный препарат бывает довольно сложно, а иногда и невозможно и вовсе.
Вывод: лечится быстро от этого недуга не получится, т. к. это всегда длительный и кропотливый процесс, и вышеперечисленные факты тому явное подтверждение. В среднем только прием антибактериальных препаратов занимает не менее 2 недель.
Как вылечить уреаплазмоз: подробная схема лечения
Схема лечения уреаплазмы как у мужчин, так и у женщин всегда базируется на антибактериальной терапии. Поэтому ураеплазмоз и его лечение, всегда базируются на этих принципах:
- Медикаменты назначают только при обнаружении воспаления и существующих симптомах.
- Обязательно назначают лечение беременной женщине, что бы исключить вертикальное инфицирование ребенка при родах.
- Прием лекарственных препаратов обязателен и при установлении факта о том, что половой партнер оказался носителем инфекции.
- Схема лечения уреаплазмоза всегда длительная, как и прием антибиотиков при ней, поэтому организм нужно поддерживать пробиотиками.
- Терапия всегда основывается на тандеме антибиотиков и иммуномодуляторов.
- На все время терапии запрещены любые половые контакты.
- На протяжении всей терапии будут проводить заборы анализов, чтобы выяснить насколько эффективно проходит лечение. Забор основного мазка всегда происходит после окончания менструального цикла, когда во влагалище обновляется вся микрофлора.
Это видео посмотрите обязательно! Альтернативное мнение нужно ли в принципе лечить уреаплазму и как с ней борются (или вовсе не замечают) в других странах.
Антибиотики при уреаплазме
Как вылечить уреаплазмоз у женщин? Только с антибиотиками:
- Тетрациклиновой группы: Доксицилин, Юнидокс. Еще 10 лет назад они были основой терапии, но сейчас их назначают только комплексно с другим антибиотиком. А все потому, что к нему бактерия быстро адаптируется.
- Группа макролипидов, на азитромициновой основе: Сумамед, Азитромицин. Это средства первой линии, которые аккумулируются в клетках, в нужной концентрации не менее 3 дней.
- Группа фторхинолонидов: Авелокс, который не может длительно аккумулироваться в клетках, поэтому их прием длительны, более 21 дня.
Важно! При невыраженном воспалении курс терапии обходится лечением только одним антибактериальным препаратом, а если оно осложненное, то лечение будет тандемное, например, чередование макролидов и тетрациклинов.
Иммуномодуляторы и не только
Как лечить уреаплазмоз у женщин? Только с использование средств, способствующих укреплению иммунитета и минимизирующих действие антибиотиков, особенно на ЖКТ. Для этого в терапии применяют следующие препараты:
- иммуномодулирующие средства то, как Уреаплазма Иммун, которая вводится путем инъекции в мышечные ткани как минимум 1 раз в 3 дня;
- бактерии для нормализации работы кишечника как лакто, так и бифидо;
- противогрибковые средства — Нистатин, как профилактика развития грибка на фоне, ослабленного антибиотиком, организма;
- витамины.
Какие свечи помогают при уреаплазмозе
В комплексной терапии этого недуга активно используют свечи двух групп:
- Антисептические, как Гексикон-Д, способствующие подавлению активности патогенных бактерий. Обычно их назначают курсом с ежедневным использованием одного суппозитория в день.
- Иммуномодулирующие, как Генферон. Средний курс 10 дней по 2 суппозитория в сутки утром и вечером.
Важно! Бытует мнение, что свечи могут полностью заменить все лекарства при этом недуге, но это неверно. Свечи — это вспомогательное средство, но никак не основное.
Народная медицина и народные средства
Уреаплазмоз можно лечить и народными способами, но только как дополнение к основной терапии и строго с согласованием у лечащего врача. Есть 7 проверенных рецептов, которые прошли испытание временем:
- Облегчить ощущение зуда и жжения поможет спринцевание сбором следующих растений: кора дуба, корень бадана, курильский чай, которые берут в равных частях. 6 ст. л. Смеси заливают крутым кипятком. Настаивают до охлаждения, процеживают и спринцуются им утром и вечером не более 2 недель.
- Теми же свойствами обладает растительный сбор из пары столовых ложек коры дуба и корня бадана, грушанки, боровой матки, которых берут по 1 ст. л. Это заливают литром кипятка, дают настоять как минимум 1 час, и спринцуются перед сном. Курс — 10 дней.
- Тампон с чесноком. Для его приготовления берут очищенный зубок чеснока, слегка накалывают его иглой и заматывают в марлю. Смочить тампон в оливковом масле и ввести во влагалище, оставив на всю ночь. Курс — 7 дней.
- Снять воспаление и восстановить микрофлору поможет настойка из золотарника. Для этого пару столовых ложек растения заливают половиной литра кипятка, и настаивают в термосе пару часов. Употреблять вовнутрь как чай четырежды в день. Курс — 30 дней.
- Смешать кору осины, корень кровохлебки, лапчатки гусиной по 100-граммовой пачке, и корень кубышки, мыльнянки по 50-граммовой пачке. Смешать и измельчить. В литре кипятка заварить 3 ст. л. смеси. После процеживания его выпивают в течение дня. Курс — 14 дней в полном объеме, после еще 16 дней, но по 0,5 литра.
- Сделать настойку из 100 грамм почек тополя, черемухи, 50 грамм чистотела и ягод можжевельника, которые настаивают на 700 мл спирта. Настаивают в темноте и тепле 14 дней. Схема приема капельная: 10 дней 3 раза по 20 капель, 10 дней 3 раза по 30 капель, и снова 10 дней с первоначальной нормой.
- Настоять 3 столовые ложки песчаной осоки в литре крутого кипятка и оставить в термосе на ночь. Принимать трижды в день по чашке. Категорически запрещен прием этого настоя беременным и кормящим.
Важно! Мы не рекомендуем вам испытывать на себе народные средства без консультации с вашим лечащим врачом.
Осложнения уреаплазмоза
Именно для представительниц прекрасного пола этот недуг может обернуться серьезными и печальными последствиями:
- Болезни мочеполовой системы: пиелонефрит, цистит, мочекаменная болезнь, уретрит.
- Воспалительные болезни матки и влагалища: эндометрит, вагинит, цевицит.
- Воспалительные болезни маточных труб, придатков, яичников.
- Потеря репродуктивной функции.
Очень опасно инфицирование уреаплазмой в период вынашивания ребенка, ведь это риск его потери, заражения в процессе родов, преждевременные роды, менингит и пневмония у новорожденного. Именно поэтому планируя беременность, нужно пройти полный врачебный осмотр, особенно у гинеколога, чтобы выявленный недуг можно было вылечить и выносить здорового и крепкого малыша.
Как вылечить уреаплазму? Только у квалифицированного врача! Других вариантов нет.
И напоследок еще одно интересное видео о уреаплазме — коммерческом диагнозе!
Смотрим и делаем выводы: уреаплазмоз — болезнь или способ на нас заработать, лечить или нет.
